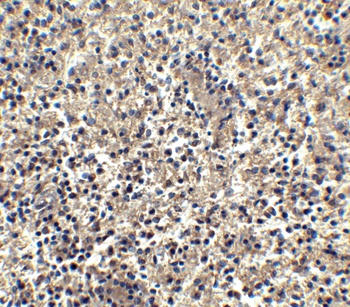
CXCR6 Antibody

You have no items in your shopping cart.
- Bonzo rabbit pAb Antibody [orb767003]Featured

ELISA, IF, IHC, WB
Human, Mouse, Rat
Polyclonal
Unconjugated
100 μl - CXCR6 Antibody [orb1239049]Featured

ELISA, IF, IHC-P, WB
Human
Rabbit
Polyclonal
Unconjugated
0.02 mg, 0.1 mg